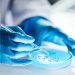
Το επικίνδυνο βακτήριο που αντιστέκεται στα φάρμακα και το νέο υπερ-αντιβιοτικό  που δίνει ελπίδα

Πρόσφατες αναλύσεις επιδημιολογικών δεδομένων στις ΗΠΑ και παγκοσμίως παρέχουν επικαιροποιημένες πληροφορίες σχετικά με το πολλαπλούν μυέλωμα (ΠΜ), μιας κακοήθειας των πλασματοκυττάρων με αυξανόμενη επίπτωση και πολύπλοκη δυναμική της θεραπείας. Οι Ιατροί της Θεραπευτικής Κλινικής (Νοσοκομείο Αλεξάνδρα) της Ιατρικής Σχολής του ΕΚΠΑ Δέσποινα Φωτίου (Επίκουρη Καθηγήτρια Παθολογικής Φυσιολογίας-Αιματολογίας), Θεοδώρα Ψαλτοπούλου (Παθολόγος, Καθηγήτρια Θεραπευτικής-Επιδημιολογίας-Προληπτικής Ιατρικής) και Θάνος Δημόπουλος (τ. Πρύτανης ΕΚΠΑ, Καθηγητής Θεραπευτικής – Ογκολογίας – Αιματολογίας, Διευθυντής Θεραπευτικής Κλινικής) συνοψίζουν τα πρόσφατα δεδομένα που δημοσιεύθηκαν από τη βάση επιδημιολογικών δεδομένων SEER των ΗΠΑ και τη μελέτη Global Burden of Disease (GBD) 2021. Οι δύο εκθέσεις παρουσιάζουν συμπληρωματικές προοπτικές σχετικά με τις τάσεις θνησιμότητας, την αποτελεσματικότητα των διαθέσιμων θεραπειών και τις γεωγραφικές ανισότητες στην επιβάρυνση της νόσου.
Τάσεις θνησιμότητας και θεραπευτικά ορόσημα στις Ηνωμένες Πολιτείες
Μια μελέτη από ερευνητές του Mass General Cancer Center εξέτασε τις τάσεις θνησιμότητας ειδικά για το ΠΜ στις Ηνωμένες Πολιτείες μεταξύ 1975 και 2022 χρησιμοποιώντας δεδομένα από τη βάση δεδομένων SEER (Surveillance, Epidemiology, and End Results). Η ανάλυση δείχνει ότι η σχετιζόμενη με το ΠΜ θνησιμότητα σε πληθυσμιακό επίπεδο έχει αλλάξει με την πάροδο του χρόνου αναλογικά με την εισαγωγή νέων θεραπειών και την αλλαγή των θεραπευτικών στρατηγικών.
Μεταξύ 1975 και 1994, η θνησιμότητα από το ΠΜ αυξήθηκε σταθερά (Ετήσια ποσοστιαία μεταβολή [APC] 1,43%) λόγω των περιορισμένων θεραπευτικών επιλογών που βασίζονταν κυρίως σε αλκυλιωτικούς παράγοντες και κορτικοστεροειδή. Η ενσωμάτωση της θεραπείας με υψηλή δόση μελφαλάνης με αυτόλογη μεταμόσχευση βλαστικών κυττάρων (ASCT) στα μέσα της δεκαετίας του 1990 συνδέθηκε με μια μέτρια μείωση της θνησιμότητας από το 1994 έως το 2002 (APC -0,70%). Μια πιο σημαντική μείωση της θνητότητας σημειώθηκε μεταξύ 2002 και 2009 (APC -1,85%), μετά την εισαγωγή των ανοσοτροποποιητικών φαρμάκων (IMiDs), όπως η θαλιδομίδη και η λεναλιδομίδη, και των αναστολέων του πρωτεασώματος (PIs), όπως η βορτεζομίμπη. Αυτές οι θεραπείες οδήγησαν σε βελτιωμένη επιβίωση χωρίς εξέλιξη της νόσου και θεωρείται ότι συνέβαλαν σημαντικά στη μείωση της θνησιμότητας.
Από το 2009 έως το 2014, οι τάσεις θνησιμότητας παρέμειναν σχετικά σταθερές (APC 0,52%), συμπίπτοντας με μια περίοδο χωρίς εγκρίσεις νέων φαρμάκων. Ωστόσο, μεταξύ 2014 και 2022, παρατηρήθηκε περαιτέρω σημαντική μείωση (APC -2,08%). Η περίοδος αυτή χαρακτηρίστηκε από τη διαθεσιμότητα πολλαπλών νεών θεραπευτικών επιλογών, συμπεριλαμβανομένων των μονοκλωνικών αντισωμάτων (π.χ. daratumumab, elotuzumab), των συζευγμένων αντισωμάτων-φαρμάκων, των θεραπειών με CAR T-κύτταρα και των ανφιειδικών αντισωμάτων έναντι νέων αντιγονικών στόχων πάνω στο κύτταρο του πολλαπλού μυελώματος.
Η μελέτη υπογραμμίζει τον πιθανό σωρευτικό αντίκτυπο της βελτιωμένης αλληλουχίας των θεραπευτικών επιλογών, της ευρύτερης χρήσης της θεραπείας συντήρησης (π.χ. λεναλιδομίδη μετά την ASCT) και της πρώιμης παρέμβασης με συνδυαστικά σχήματα, ιδίως τριπλές ή τετραπλές θεραπείες, ως παράγοντες που συμβάλλουν στην παρατηρούμενη μείωση της θνησιμότητας.
Παρά τις βελτιώσεις αυτές, οι συγγραφείς σημειώνουν συνεχιζόμενες ανησυχίες σχετικά με τις τοξικότητες που σχετίζονται με τη θεραπεία, το κόστος και τις ανισότητες πρόσβασης, οι οποίες ενδέχεται να επηρεάσουν τα αποτελέσματα σε διαφορετικούς πληθυσμούς ασθενών.
Συμπληρώνοντας την ανάλυση με επίκεντρο τις ΗΠΑ, μια δεύτερη έκθεση που βασίζεται στο σύνολο δεδομένων της GBD 2021 παρέχει μια παγκόσμια επισκόπηση του ΠΜ από το 1990 έως το 2021, με προβλέψεις έως το 2040. Η ανάλυση αυτή εξέτασε την επίπτωση, τη θνησιμότητα και τα προσαρμοσμένα στην αναπηρία έτη ζωής (DALYs) σε 204 χώρες και περιφέρειες, διαστρωματωμένα κατά φύλο, ηλικία και κοινωνικοδημογραφικό δείκτη (SDI).
Σύμφωνα με τα ευρήματα, ο παγκόσμιος αριθμός των νέων κρουσμάτων του ΠΜ αυξήθηκε από περίπου 56.000 το 1990 σε σχεδόν 149.000 το 2021. Ο προσαρμοσμένος κατά ηλικία δείκτης επίπτωσης (ASIR) αυξήθηκε από 1,5 σε 1,7 ανά 100.000 κατοίκους κατά τη διάρκεια αυτής της περιόδου (εκτιμώμενη ετήσια ποσοστιαία μεταβολή [EAPC] 0,48), υποδεικνύοντας σταδιακή ανοδική τάση. Το 2021, εκτιμάται ότι το ΠΜ προκάλεσε περισσότερους από 116.000 θανάτους παγκοσμίως, με τον τυποποιημένο κατά ηλικία ρυθμό θανάτου (ASDR) να αυξάνεται ελαφρώς σε 1,4 ανά 100.000 άτομα (EAPC 0,15).
Η παγκόσμια επιβάρυνση από το ΠΜ, όπως μετράται με βάση τα DALYs, αυξήθηκε επίσης ελαφρά, από 28,3 ανά 100.000 άτομα το 1990 σε 30,0 το 2021 (EAPC 0,06). Οι άνδρες και τα ηλικιωμένα άτομα αντιπροσώπευαν δυσανάλογο μερίδιο του φορτίου της νόσου, σύμφωνα με τα καθιερωμένα επιδημιολογικά πρότυπα.
Η μελέτη αναδεικνύει σημαντικές γεωγραφικές διαφορές. Οι περιοχές με υψηλό δείκτη SDI -όπως η Βόρεια Αμερική, η Δυτική Ευρώπη και η Αυστραλασία- είχαν τα υψηλότερα ποσοστά επίπτωσης, αλλά παρουσίασαν επίσης μειωμένη ή σταθερή θνησιμότητα και DALYs, γεγονός που υποδηλώνει βελτιώσεις στην αποτελεσματικότητα της θεραπείας και την πρόσβαση στην υγειονομική περίθαλψη. Αντίθετα, οι περιοχές με μεσαίο και χαμηλό δείκτη SDI ανέφεραν αύξηση της θνησιμότητας και της επιβάρυνσης από τη νόσο με την πάροδο του χρόνου.
Στις χώρες με υψηλό-μεσαίο και μεσαίο δείκτη SDI, τόσο τα ποσοστά επίπτωσης όσο και τα ποσοστά θανάτου αυξήθηκαν σημαντικά, με EAPC για την επίπτωση να ξεπερνούν το 1,5 σε αρκετές περιοχές. Για παράδειγμα, η Κεντρική Ασία, η Νότια Ασία και η Ανατολική Ευρώπη ανέφεραν αύξηση της επίπτωσης και της θνησιμότητας του ΠΜ, υπογραμμίζοντας τις προκλήσεις που σχετίζονται με τις υποδομές υγειονομικής περίθαλψης και τη διαθεσιμότητα πόρων.
Αντίθετα, ορισμένες περιοχές υψηλού εισοδήματος, όπως η Βόρεια Αμερική και η Ασία-Ειρηνικός, κατέδειξαν αρνητικούς EAPC για τη θνησιμότητα και τα DALYs, υποδεικνύοντας πιθανά οφέλη από την εισαγωγή νέων θεραπειών και την υποστηρικτική φροντίδα. Αυτές οι τάσεις υποδηλώνουν ότι, ενώ οι διαγνωστικές βελτιώσεις μπορεί να εξηγούν την αύξηση της επίπτωσης σε ορισμένες περιοχές, η καλύτερη πρόσβαση στη θεραπεία έχει μετριάσει τη θνησιμότητα σε άλλες.
Παράγοντες κινδύνου και μελλοντικές προβλέψεις
Η μελέτη GBD εξέτασε επίσης πιθανούς παράγοντες κινδύνου που σχετίζονται με το ΠΜ, εντοπίζοντας τον υψηλό δείκτη μάζας σώματος (ΔΜΣ) ως τον σημαντικότερο τροποποιήσιμο παράγοντα. Άλλοι παράγοντες, συμπεριλαμβανομένης της γήρανσης του πληθυσμού και της βελτιωμένης διαγνωστικής επιτήρησης, συνδέθηκαν επίσης με τις παρατηρούμενες τάσεις στην επιβάρυνση της νόσου.
Χρησιμοποιώντας ένα μοντέλο ηλικίας-περίοδο-συνόλων κατά Bayes, οι προβλέψεις υποδηλώνουν ότι, ενώ η παγκόσμια επίπτωση του ΠM μπορεί να συνεχίσει να αυξάνεται μέτρια τα επόμενα χρόνια, τα ποσοστά θνησιμότητας και DALY θα μπορούσαν να σταθεροποιηθούν ή να μειωθούν σε περιοχές με υψηλό δείκτη SDI, εάν τα τρέχοντα θεραπευτικά πρότυπα παραμείνουν και γίνουν ευρύτερα προσβάσιμα.
Τα ευρήματα υποδεικνύουν την αυξανόμενη ανάγκη για στρατηγικές προσαρμοσμένες ανά γεωγραφική περιοχή. Στις περιοχές με χαμηλό και μεσαίο δείκτη SDI, όπου η επιβάρυνση από το ΠΜ αυξάνεται και η πρόσβαση στη θεραπεία παραμένει περιορισμένη, οι βελτιώσεις του συστήματος υγείας, η διαχείριση των παραγόντων κινδύνου και η έγκαιρη ανίχνευση μπορούν να συμβάλουν στη μείωση των ανισοτήτων. Στις χώρες με υψηλότερο εισόδημα, η εστίαση αναμένεται να μετατοπιστεί προς τη μακροχρόνια φροντίδα επιβίωσης, τη διαχείριση των επιπλοκών που σχετίζονται με τη θεραπεία και τη βελτιστοποίηση της σχέσης κόστους-αποτελεσματικότητας των θεραπειών.
Συμπερασματικά, οι δύο αυτές εκθέσεις παρέχουν μαζί μια ολοκληρωμένη επισκόπηση της επιδημιολογίας του ΜΜ σε εθνικό και παγκόσμιο επίπεδο. Στις Ηνωμένες Πολιτείες, η μείωση της θνησιμότητας του ΜΜ κατά τις τελευταίες δύο δεκαετίες φαίνεται σχετίζεται στενά με τις θεραπευτικές εξελίξεις. Σε παγκόσμιο επίπεδο, το βάρος της νόσου παραμένει σημαντικό και συνεχίζει να αυξάνεται σε πολλά μέρη του κόσμου, ιδίως σε περιοχές με περιορισμένη πρόσβαση σε νέες θεραπείες και υποδομές υγειονομικής περίθαλψης.
Οι μελλοντικές προσπάθειες μπορεί να ωφεληθούν από στοχευμένες πρωτοβουλίες δημόσιας υγείας που αντιμετωπίζουν τροποποιήσιμους παράγοντες κινδύνου, ενισχύουν την πρόσβαση σε διαγνωστικές και θεραπευτικές καινοτομίες και βελτιώνουν την υποστηρικτική φροντίδα σε όλο το φάσμα της νόσου. Αυτές οι δράσεις θα μπορούσαν να συμβάλουν σε μια πιο ομοιόμορφη μείωση της παγκόσμιας επιβάρυνσης από το ΠΜ και σε βελτιωμένα αποτελέσματα σε διαφορετικούς πληθυσμούς ασθενών.